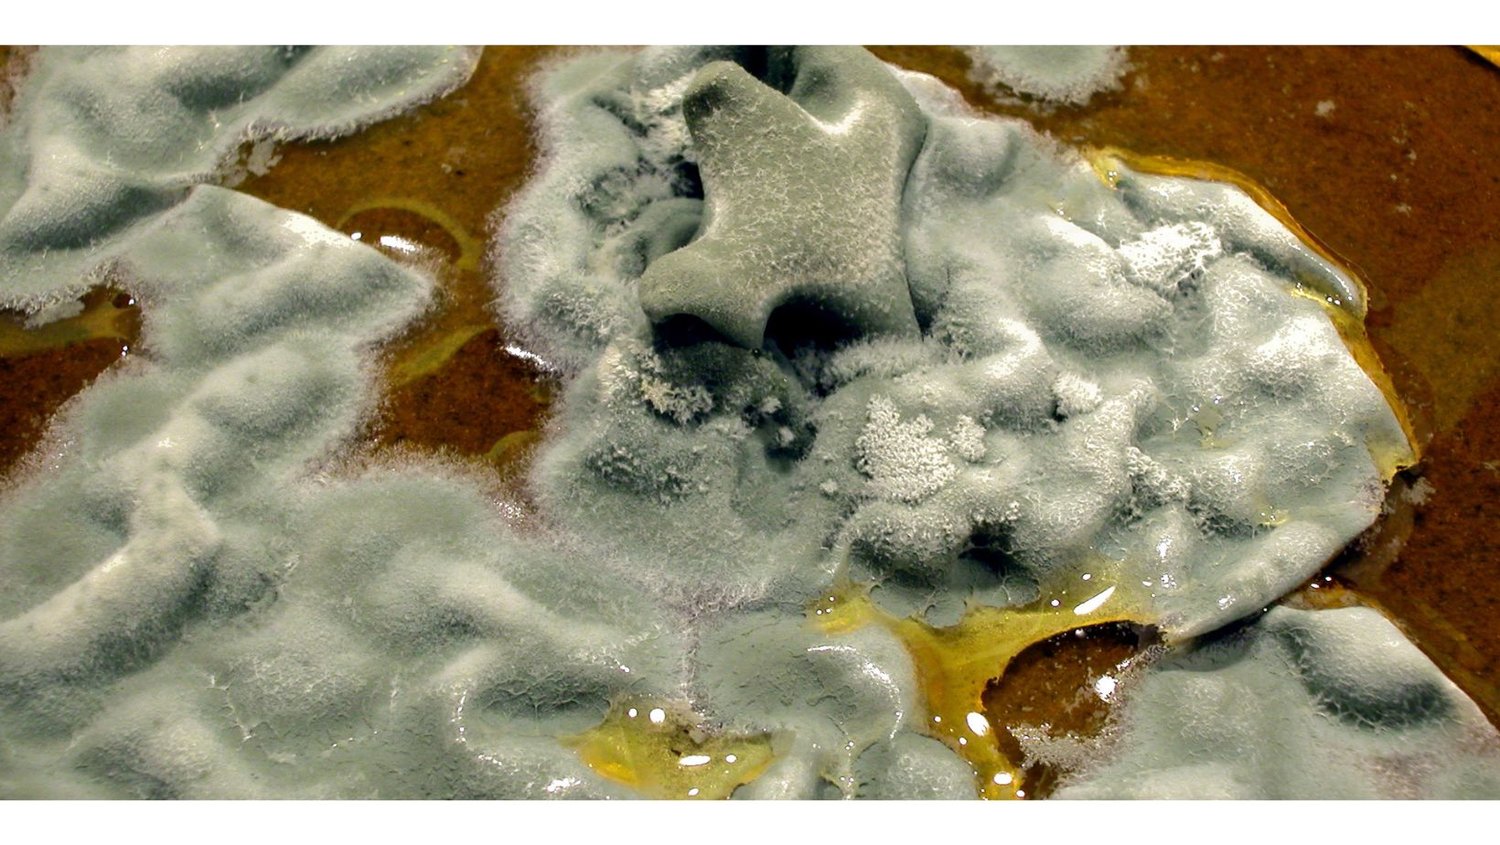

Identificación Taxonómica con Microscopía
Hongos filamentosos
Cianobacterias
Microalgas

¡Bienvenido!
Este curso está diseñado para sumergirte en la diversidad y complejidad de estos microorganismos, explorando sus características morfológicas, fisiológicas y ecológicas. Desde los misteriosos hongos que tejen su red en la oscuridad del suelo, hasta las diminutas microalgas que pintan de verde los cuerpos de agua, y las cianobacterias que transforman la energía solar en vida, cada uno de estos organismos juega un papel vital en los ecosistemas del planeta. A lo largo de este viaje, desarrollarás habilidades prácticas para reconocer y clasificar estas formas de vida, explorando su importancia en campos que van desde la investigación científica hasta la biotecnología y la conservación del medio ambiente. ¡Prepárate para sumergirte en un universo microscópico repleto de maravillas y desafíos!
Participa de este taller no te quedes fuera
Fecha de inicio: 8 de Junio 2024 Hongos filamentoso.
Fecha de inicio: 9 de junio 2024 Cianobacteria y microalgas.
Curso asincrónico incluye videos de todas las prácticas de laboratorio y atlas de identificación!
Fecha de finalización del curso: Segunda semana de Julio 2024.
Webinar para dudas y consultas al igual de revisión de información Segunda semana de Julio 2024.
Técnicos Responsables
Conoce al equipo técnico que hará que tu experiencia en este curso sea excepcional. Nuestro equipo está compuesto por expertos en taxonomía de hongos filamentosos, microalgas y cianobacterias, con una pasión contagiosa por el mundo microscópico. Están listos para guiarte en cada paso del camino, desde la identificación de especies hasta la comprensión de sus funciones ecológicas. Con su experiencia y dedicación, te inspirarán a explorar y descubrir los secretos de estos fascinantes organismos. ¡Únete a nosotros y déjate sorprender por el conocimiento y la pasión de nuestro equipo técnico!


Course curriculum
-
1Unidad 1 Mohos filamentosos
-
2Prácticas mohos filamentosos
-
3Unidad 2 Algas y cianobacterias
-
4Prácticas microalgas y cianobacterias
Certificado
Al finalizar el taller te enviarémos este certificado a tu correo electrónico.

Imágenes del Taller Presencial